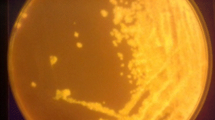

Abstract
The current manuscript focuses on the isolation of a potent lipase-producing mesophilic bacteria and explores the optimization of culture parameters to enhance lipase production. From a total of 83 bacterial isolates, after screening on tributyrin agar plate, rhodamine olive oil agar plate, and submerged fermentation studies, the isolate VT 1 with a lipase activity of 23.85 U/mL was selected. The potent isolate VT 1 was identified as Serratia marcescens (accession number OM757842) based on 16S rRNA gene sequencing and standard morphological and biochemical procedures. The lipase production was optimized by a statistical approach using response surface methodology after identifying the significant factors with Plackett-Burman design using Design-Expert, version 11 software. Nutrient factors- peptone, yeast extract, sodium chloride, and olive oil- were identified as the significant factors. Its optimization via central composite design of response surface methodology with Design-Expert, version 11 (olive oil: 50 mL/L, sodium chloride: 8.87 g/L, peptone: 8.15 g/L, yeast extract: 10 g/L) resulted in an enhanced experimental lipase activity of 55.95 U/mL in comparison to the predicted lipase activity of 56.858 U/mL. The study brought forth the isolation of a lipase-producing Serratia marcescens strain VT 1 and highlighted the importance of optimizing culture parameters for augmented production of lipase. The optimization via response surface methodology resulted in a 2.34-fold increase in lipase production.
Similar content being viewed by others
Avoid common mistakes on your manuscript.
Introduction
Triacylglycerol acylhydrolases (EC 3.1.1.3), classically referred to as lipase, is a hydrolase known to act in nonaqueous and aqueous media, hydrolyzing lipids in a substrate-water interface (Nehal et al. 2019; Nadeem et al. 2021; Patel et al. 2021). The primary physiological function of lipase is lipid turnover and cellular metabolism in all living forms. They are essential for mobilizing stored lipids in endosperms, assisting seed germination, and in pathogens, are considered virulence factors (Wang et al. 2018; Saha et al. 2023). Aside from classical hydrolysis, they efficiently catalyze the synthetic reverse reactions like esterification, transesterification, and aminolysis, which has gained lipase its importance as an industrial biocatalyst (Nadeem et al. 2021; Priyanka et al. 2020; Vaisee et al. 2016). All these hydrolytic and synthetic reactions, along with high stability under assorted temperatures, pH, organic solvents, and an array of substrate specificity, along with regiospecific and stereospecific properties, add to the significance of lipase in various biotechnological and industrial applications (Aziz et al. 2020; Vaisee et al. 2016; Sharma et al. 2014). Despite having omnipresence, the industrially utilized lipases are predominantly microorganism-based: bacteria, fungi, and yeast, as they are easy to handle and genetically modify and show a wide range of characteristic properties which allows the selection of suitable ones for specific reactions (Nehal et al. 2019). Lipase-producing microbes live in diverse habitats, and researchers have isolated and identified them from various sources, which also adds to the diverse characteristic properties of this industrially important enzyme (Adetunji and Olaniran 2018, Vivek et al. 2022).
Humans have been studying the heterogeneous microbial community to discover novel sources of lipases, and have isolated, purified, characterized, and determined the industrial potential of many in dairy and food, health and pharmaceuticals, textiles, tanneries, detergents, paper industry, perfumery, cosmetics, bioremediation, sewage treatment, and biodiesel and biolubricant production (Nehal et al. 2019; Sahoo et al. 2021; Vivek et al. 2022). Despite such vast studies, the efficient application of lipases in industries is meager, and one prime limiting factor is the high expense accompanied by their production (Sahoo et al. 2021). The industrial application needs enzymes like lipase in huge quantities and the quality is further dependent on the kind of application, which makes industrial biocatalysis a challenging task. Therefore, it is important to make the synthesis of enzymes economical by making use of inexpensive substrates and nutrients and production technologies that are cost-effective (Sahoo et al. 2021). This can be accomplished by using good lipase producers and use of optimization techniques for optimizing the lipase production media by adopting the best substrates, nutrients, and salts at distinct concentrations, along with perfect operational attributes: temperature, pH, agitation speed, oxygen concentration, medium volume, inoculum size, and incubation time for augmented and profitable production (Adetunji and Olaniran 2018; Sahoo et al. 2021). Extracellular enzyme secretion relies on the strain, media formation, and physical parameters (Eddehech et al. 2019). Media optimization can be attained by one factor/variable at a time (OFAT/OVAT) method, a statistical approach using design of experiments (DOE), or a combination of both.
OFAT method is a predominant and established classic technique where one factor is varied at a time, keeping the residual constant. Although it is effective, there are some associated drawbacks, like the expense and time required for carrying concurrent steps for numerous factors and the ineffectiveness of delineating the effect of interactions among factors and ideal facets between factors (Adetunji and Olaniran 2018). DOE, the statistical experimental approach, including Plackett-Burman design (PBD) and response surface methodology (RSM), can overcome these problems and has been employed to evaluate and optimize the factors for lipase enrichment (Sahoo et al. 2021). DOE gives more precise inferences than the OFAT method, decreases the number of trials, and provides extra informative datasets based on multiple-factor interactions to improve the overall experiment (Pereira et al. 2021). PBD, an uncomplicated, reliable, and fast method, analyses the effect of numerous parameters to evaluate and figure out the significant ones affecting the process in a single step (Aziz et al. 2020; El-Naggar et al. 2016). RSM, a collection of mathematical and statistical techniques, helps significantly reduce the number of experimental runs, identify the influence of each experimental factor and their interactions, and select the optimum conditions. RSM helps to improve the output of a process without changing the involved factors, giving a predicted output closer to the actual experimental runs (Patel et al. 2021; Adetunji and Olaniran 2021). Central composite design (CCD), a standard RSM design, is used when the experimental design has factors that are delimited by an upper and lower value. PBD and RSM (CCD) have resulted in enhanced lipase production and optimization of lipase-catalyzed reactions (Patel et al. 2020, 2021; Ahmed et al. 2021; Shahedi et al. 2019).
The industrial demand for lipolytic biocatalysts with formidable activity and stabilities has been an all-time need that prompted the necessity for studies concerning the isolation of new lipases and their enhancement by optimization, genetic improvement, and immobilization strategies. Psychrophilic lipases capable of methyl ester synthesis by transesterification of waste lipids are of great industrial importance (Vivek et al. 2023). Thus, the main objective of the current study was the augmented production of a novel cold-active and stable lipase with transesterification properties from a mesophilic soil bacterial isolate by optimization of the production media by a statistical method using Design-Expert software. Eight different variables, comprising nutritional and physical parameters, were considered for the study based on OFAT experiments (Vivek et al. 2021). The significant factors were identified based on PBD and further optimized by CCD of RSM to determine the optimum concentration and combination of the selected operational parameters to enhance the extracellular lipase secretion.
Materials and methods
Materials
Peptone, yeast extract, and agar of bacteriological grade, sodium chloride, Tris HCl, olive oil, gum arabic, tributyrin, Rhodamine B (practical grade), and Triton-X 100 were obtained from HiMedia, India. 4-nitrophenol palmitate, and 4-nitrophenol were purchased from Sigma-Aldrich, USA. All other chemicals used in the study were of analytical grade. Equipment used: Spectrophotometer: UV-VIS spectrophotometer type 108 Systronics, pH meter: Labtronics LT-10, centrifuge: REMI CPR-24 Plus, shaker: REMI RS-24BL, electronic weighing balance: Shimadzu AUY 220, thermal cycler: GeneAmp PCR System 9700, Applied Biosystems. Softwares: Design-Expert -v11 software from Stat-Ease, BLASTN tool, National Center for Biotechnology Information (NCBI), and MEGA11 (Molecular Evolutionary Genetics Analysis version 11).
Collection of soil samples
Soil samples contaminated with oil and other lipid sources were collected from eighteen different localities of the Thiruvananthapuram district in Kerala. The collection sites included restaurants, oil mills, petrol pumps, automobile garages, landfill sites, and temples. Topsoil was collected using sterilized spatulas in sterile plastic containers and stored at 4 °C before enrichment.
Enrichment of lipase producing bacteria
For enhanced growth and isolation of lipolytic bacteria, the soil samples were put through enrichment. 5 g of soil samples were mixed with 50 mL of sterilized distilled water. 5 mL of this suspension was transferred to 45 mL of sterilized enrichment media comprising olive oil as fundamental lipid and carbon source (yeast extract (0.05% w/v), peptone (0.05% w/v), NaCl (0.05% w/v) & olive oil (2% v/v)). The media was incubated in a rotary shaker at 120 rpm at 30 °C for 72 h. 5 mL of these enriched culture were subjected to an additional round of enrichment under similar conditions, except that the concentrations of yeast extract and peptone were halved.
Isolation and screening for lipolytic bacteria
1 mL of the enriched medium was subjected to serial dilution and spread onto nutrient agar plates composed of yeast extract (0.5% w/v), peptone (0.5% w/v), NaCl (0.5% w/v), and agar (2% w/v). The plates were incubated at 37 °C for 24 h. The isolates obtained were further subcultured in nutrient agar plates to obtain pure colonies. The isolates obtained were then subjected to two-level screening tests for extracellular lipase activity. First, the bacterial isolates were plated on Tributyrin agar (TBA) plates composed of peptone (0.5% w/v), yeast extract (0.3% w/v), agar (2% w/v), and tributyrin (1% v/v), pH 7.5 (Kumar et al. 2012). The plates were incubated for 48 h at 37 °C and observed for clear zone (Sztajer et al. 1988). The isolates showing prominent clear zones were subjected to secondary screening on Rhodamine olive oil agar (ROA) plates incorporating nutrient broth (0.8% w/v), NaCl (0.4% w/v), Rhodamine B (0.001% w/v), olive oil (3% v/v), and agar (2% w/v), pH 7.5 (Castro-Ochoa et al. 2005). Plates were incubated at 37 °C for 48 h. The presence of fluorescent orange halos visible under UV light confirmed extracellular lipase production.
Maintenance of culture
The lipase-positive isolates were maintained in nutrient agar plates supplemented with olive oil (0.3% v/v) and stored at 4 °C. Stock cultures were subcultured at regular intervals of 2 weeks.
Lipase production
The pre-inoculums were prepared by transferring a loop of 24 h-old culture into 50 mL of nutrient broth in 250 mL Erlenmeyer flasks in a rotary shaker at 120 rpm at 30 °C. The composition of lipase production media was yeast extract (0.5% w/v), NaCl (0.5% w/v), peptone (0.5% w/v), olive oil (1% v/v), and pH 7 for 100 mL (Selvamohan et al. 2012). 10 mL of pre-inoculum was transferred to 90 mL of production medium in 250 mL Erlenmeyer flasks. The cultures were incubated at 30 °C on a rotary shaker at 120 rpm, and samples were collected at a regular interval of 24 h. The culture was made cell-free by centrifugation at 8000 rpm for 20 min at 4 °C, and the supernatant was used as an enzyme source.
Lipase assay
Lipase activity was determined colorimetrically using 4-Nitrophenyl palmitate (PNPP) as substrate (Yagiz et al. 2007). 0.1 mL of crude enzyme extract was mixed with 0.9 mL of reaction mixture containing 3 mg PNPP dissolved in 1 mL of propane-2-ol diluted in 9 mL of 50 mM Tris HCl (pH 8) containing 40 mg Triton X- 100 and 10 mg of Gum arabic. The above mixture was incubated at 37 °C for 30 min. The release of 4-Nitrophenol was measured at 410 nm against a blank containing buffer under the described conditions using UV-VIS spectrophotometer type 108 (Systronics). One unit of enzyme activity was defined as the amount of enzyme that released 1 µmol of 4-Nitrophenol per minute from the substrate. 4-Nitrophenol was used as the standard.
Protein determination
Protein was assayed based on standard procedure (Lowry et al. 1951). Bovine Serum Albumin was used as the standard.
Identification of the potent isolate
The isolate was subcultured onto a nutrient agar plate supplemented with olive oil and incubated for 3 days at 37 °C. The morphological characters of the microbial colonies were described by colour, surface, configuration, elevation, margin, and density. The cell morphology and spore formation were determined by light microscopy. Gram staining was performed (Smith and Hussey 2005). The isolate was identified according to ‘Bergey’s Manual of Determinative Bacteriology’ and matrix-assisted laser desorption/ionization time-of-flight mass spectrometry (MALDI-TOF MS) profiling with the MALDI Biotyper software and database (Bruker) at the Microbial Type Culture Collection and Gene Bank (MTCC), Chandigarh, India.
Further, 16S ribosomal ribonucleic acid (rRNA) gene sequencing of the isolate was performed. The NucleoSpin® Tissue Kit (Macherey-Nagel) was used to isolate Genomic DNA. PCR (polymerase chain reaction) thermal cycler (GeneAmp PCR System 9700, Applied Biosystems) was used for PCR amplification. The reaction targeted the 16S rRNA gene, with the Forward primer 16S-RS-F (CAGGCCTAACACATGCAAGTC 5’ → 3’) and the Reverse primer 16S-RS-R (GGGCGGWGTGTACAAGGC 5’ → 3’). The sequencing reaction utilized the BigDye Terminator v3.1 Cycle sequencing Kit (Applied Biosystems, USA) in a PCR thermal cycler (GeneAmp PCR System 9700, Applied Biosystems). The PCR amplification profile involved 35 cycles: initial denaturation at 95 °C (5 min), denaturation at 95 °C (30 s), annealing at 60 °C (40 s), extension at 72 °C (60 s), final extension at 72 °C (7 min), and final hold at 4 °C (∞). Sequence quality assessment was conducted using the Sequence Scanner Software v1 by Applied Biosystems. Sequence alignment and necessary editing of the obtained sequences were carried out using Geneious Pro version 5.1 software from Biomatters Ltd. (Drummond et al. 2010). The obtained 16S rRNA gene sequence was analyzed using the BLASTN tool (Altschul et al. 1990) available in the GenBank database of the NCBI. Furthermore, sequence alignment was conducted using ClustalW, and the phylogenetic tree was constructed and analyzed using MEGA11 software (Tamura et al. 2021) through the neighbour-joining tree method with a bootstrap value of 1000. The gene sequence was deposited in NCBI with accession number OM757842.
Optimization of lipase production media
Statistical optimization of the media was carried out by DOE using Design-Expert, version 11 software package from Stat-Ease Inc.
Determination of significant factors- PBD
PBD was used to determine the significant variables contributing to lipase secretion based on their main effects, neglecting their interactions. Eight different parameters, comprising 4 media components (olive oil, peptone, yeast extract, and NaCl) and 4 physical parameters (agitation speed, inoculum size, medium volume, and pH) were evaluated in the 12-run experiment. To meet the total number of factors (11), three dummy variables, D1, D2, and D3, were used. All the variables were evaluated in two levels; high level (1) and low level (-1). Table 1 shows the two levels of all the parameters analyzed. The 12-run experiment was carried out in triplicate based on the design. Enzyme assays were conducted, and the mean of each run was considered the corresponding response. Analysis of the experimental data was performed using analysis of variance (ANOVA) to estimate the effect of each variable. The following equation (Eq. 1),
was used to evaluate the effect of each variable to determine its significance. Here, E represents the effect of the studied variable, N is the number of performed experiments, and M+ and M− are the responses (enzyme activity) of experimental runs where the variables were at their 1 and − 1 levels, respectively.
Optimization of the significant variables- CCD
RSM was utilized to optimize the four significant factors identified by PBD. CCD was performed to determine the level of each identified factor resulting in optimum enzyme activity. The selected variables were studied by a five-level quadratic design (-α, -1, 0, 1, and α), and the coded and actual levels of the four significant parameters are shown in Table 1. The design generated by CCD for the selected four significant variables was a 24 full factorial quadratic model consisting of 8 axial points, 6 center points, and 16 factorial points, thus making a 30-run experiment. A quadratic equation was used to calculate enzyme activity (response), and multiple regression was applied. Effects of each variable, including the linear, quadratic, and interaction terms, on the dependent response were estimated, and insignificant ones were discarded to improve the model fitness. The quadratic equation (Eq. 2) explaining the behaviour of the significant variables on enzyme activity is given by
where Y denotes the predicted response, \({\beta }_{0 }\) the intercept term and \({\beta }_{i}\), \({\beta }_{ii}\), and \({\beta }_{ij}\) the linear, quadratic, and interaction coefficients of the corresponding variables \({X}_{i}\), \({X}_{i}^{2}\), and \({X}_{i}{X}_{j}\) where X can be A, B, C, and D.
All 30 trial runs were carried out in triplicate based on the CCD’s media composition. Contour and 3D response plots were generated to understand the effect of variables on lipase production, based on the polynomial quadratic equation. Numerical optimization was performed to optimize the lipase production, and the goal was to maximize the lipase synthesis within the studied range.
Validation of the optimization experiment
Submerged fermentation and assay experiments were conducted in the lab to confirm the adequacy of the model in optimizing lipase production. The media were prepared as per the composition predicted by the CCD, resulting in the best lipase activity, and the strain Serratia marcescens VT 1 (SMVT 1) was used as the lipase source. The in vitro experimental values were compared with the predicted value of lipase activity given by Design-Expert, version 11, to validate the optimization study.
Statistical analysis
All experimental runs were conducted in triplicate for all procedures. The optimization study results underwent ANOVA analysis using Design-Expert, version 11, while the remaining data were analyzed using MS Excel.
Results and discussion
Isolation of lipase producing bacteria
Search for new sources of lipase with novel characteristics suited for industrial application is essential to meet the ever-growing demand. The selection of the potent isolate was centered on the production of clear zones and orange fluorescent halos after primary and secondary screening and quantification of extracellular lipase. A total of 83 bacterial isolates were isolated and purified from the enriched media. During primary screening, 40 isolates produced clear zones assignable to tributyrin hydrolysis in TBA plates. In secondary screening, orange fluorescent halos were observed for 17 isolates indicating extracellular lipase production, which were eventually made liable to submerged fermentation and lipase quantification. TBA plates and ROA plates are reported to be utilized for screening and isolating extracellular lipase-producing microbes (Abol-Fotouh et al. 2016; Ramnath et al. 2017; Abol-Fotouh et al. 2021). The clear zones on TBA plates owing to hydrolysis of tributyrin perceived the presence of either lipase or esterase. Both lipases and esterases are noted for hydrolysis of carboxylic ester bonds, but their choice of substrates differs depending on the length of the fatty acid chain (Ramnath et al. 2017). To affirm the presence of lipase, secondary screening by ROA plates was performed. Olive oil, on hydrolysis by lipase, culminates in free fatty acids, which couple with Rhodamine B, resulting in a fluorescent complex under UV light (Sharma et al. 2014). Kouker and Jaeger (1987) identified Pseudomonas aeruginosa ATCC 9027, Serratia marcescens, Serratia aureus, and Bacillus subtilis as lipase producers on ROA plates. Geobacillus stearothermophilus FMR12 and Geobacillus thermoleovorans DA2, both producing lipases, were isolated from desert, soil, and water samples using TBA and ROA plates (Abol-Fotouh et al. 2016; Abol-Fotouh et al. 2021). Bacterial colonies producing larger halos on ROA plates show higher lipase activity (Vaisee et al. 2016). Out of the 17 isolates highest lipolytic activity was displayed by VT 1 (16.82 U/mL), subsequently PP1 (13.21 U/mL) and V2 (11.03 U/mL), and minimal activity was shown by P3 (1.98 U/mL) after 48 h of incubation (Fig. 1a).
The isolate VT 1 showed maximum lipase activity (Fig. 1b) of 23.85 U/mL at 24 h of incubation at 30 °C. At 96 h, the activity was 21.36 U/mL, whereas the least amount of activity was observed at 72 h (12.35 U/mL). The increase in lipase activity at 96 h may be due to the release of intracellular lipase into the medium via cell lysis or might happen from the possibility of diauxic/diphasic growth shown by VT 1 as an adaptive measure in the presence of multi-nutrient medium to increase the population growth (Gupta and Kar 2009; Chu and Barnes 2016; Triyaswati and Ilmi 2020). For Serratia marcescens MBB05, the optimal incubation period for lipase production was reported to be 20 h (Abdou 2003). Lipase production is known to start succeeding the logarithmic phase in the growth curve, which typically takes about 5–10 h of cultivation (Duzhak et al. 2000). Based on 4-Nitrophenol generation, isolate VT 1 was selected among the 17 for further study. The isolate VT 1 and the results of the primary and secondary screening for VT 1 are shown in Fig. 2a, b, and c.
Identification of lipase producing isolate VT 1
The potent isolate VT 1 was identified based on standard morphological and biochemical characterization, MALDI- Biotyper profiling, and molecular identification using 16S rRNA gene sequencing. In terms of morphological characteristics, the single colonies of VT 1 exhibited an opaque, raised appearance on the medium, irregular margins, smooth surfaces, and red coloration. The isolate was identified as Gram-negative and rod-shaped through Gram staining and microscopic analysis, with no observed endospore formation. The isolate VT 1 showed growth within a temperature range of 10–42 °C, while growth was inhibited at 50 and 55 °C. Additionally, VT 1 exhibited growth within a pH range of 5–9 and a wide range of NaCl concentrations from 2 to 9%. Biochemical test indicated growth on MacConkey agar medium and was positive for indole test, citrate test, casein test, and catalase production. This indicates the ability to utilize citrate as a carbon source, produce indole from tryptophan, break down casein, and produce catalase enzyme, respectively. Conversely, the isolate VT 1 tested negative for the Methyl Red test, Voges-Proskauer test, starch hydrolysis, oxidase, urease, and H2S gas production, suggesting the absence of specific metabolic pathways or enzyme activities associated with these tests. Among the carbohydrates tested, fructose, salicin, mannitol, trehalose, sorbitol, and sucrose resulted in acid synthesis when utilized by the isolate VT 1, indicating its ability to ferment those sugars into acidic byproducts. On the other hand, raffinose, cellobiose, rhamnose, xylose, lactose, galactose, and inositol were not fermented by VT 1. Based on morphological and biochemical characterization results, it could be inferred that the isolate VT 1 exhibited the closest similarity to the genus Serratia. The results are in agreement with previous studies (Abdullah et al. 2017; Abdhul et al. 2018; Zhang et al. 2020).
With respect to the MALDI-TOF spectrum (Fig. 3) of VT 1, a score value of 2.275 within the range of 2.300-2.299 was observed, indicating a confident genus identification and a probable species assignment as Serratia marcescens. MALDI-TOF MS, a rapid and reliable technique for microbial identification, generates a ‘‘molecular fingerprint’’, a distinctive proteomic spectrum and relies on pattern recognition algorithms provided in software comparing them against a database to allocate corresponding scores for identification (Kedney et al. 2007; Maier et al. 2006; Ng 2018). The conserved mass peaks of Serratia marcescens are observed at 2826, 3962, 4185, 4349, 4606, 4768, 5359, 6116, 6226, 7924, and 9537 m/z (Ng 2018). Additionally, mass peaks at m/z 3603, 5496, 6800, 8858 and 9531 serve as biomarkers for Serratia marcescens (Ahmad and Wu 2012). Similar mass peaks were observed during the MALDI-TOF MS of VT 1. Finally, complementary identification was achieved by utilizing the nucleotide sequences of the 16S rRNA gene analysis and the construction of a phylogenetic tree (Fig. 4). The 1500 bp 16S rRNA gene of VT 1 was specifically targeted and sequenced using designated reverse and forward primers. The resulting 707 bp partial sequence was then subjected to a BLASTN search for comparison with the NCBI database. The BLASTN search of the 16S rRNA gene sequence revealed that VT 1 exhibited a 99.86% similarity with partial sequences of Serratia marcescens (accession number: MN691696, MN691691, MN691619) and the complete genome of Serratia marcescens (accession number: CP123597, CP123607). Subsequently, the phylogenetic tree of VT 1 was constructed using its 16S rRNA gene sequence and homologous gene sequences. These sequences were obtained through BLASTN analysis, followed by multiple sequence alignment with ClustalW. The phylogenetic analysis was performed using MEGA11 software, employing the neighbour-joining tree method with 1000 bootstrap values. The results of the phylogenetic tree analysis confirmed the placement of isolate VT 1 within the branches that encompass Serratia marcescens strains, providing evidence that the isolate VT 1 belongs to the genus Serratia and the species marcescens. Extracellular lipase from Serratia marcescens has been reported previously (Prasad 2013; Begam et al. 2012; Gupta et al. 2013; Luz et al. 2021). Prasad, 2013 reported a maximum activity of 6.102 U/mL for S. marcescens after 45 h at 30 °C and pH 7. Gupta et al. 2013 and Begam et al. 2012 observed maximum lipolytic activity of 13.3 U/mL and 1 U/mL for S. marcescens MBB05 and S. marcescens SN5gR, respectively. Luz et al. 2021 reported 3.85 U/mL of lipase activity after 96 h for S. marcescens isolated from bromeliad. SMVT 1 exhibited nearly double the maximum lipase activity (23.85 U/mL) at 24 h, and the minimum activity observed at 72 h (12.35 U/mL) almost matched the maximum activity of 13.3 U/mL reported for S. marcescens MBB05.
Statistical optimization of SMVT 1 lipase
Lipases, known to be inducible, have their synthesis influenced by nutritional and cultural parameters (Zaki and Saeed 2012). To understand the effect of eight different nutritional and physical parameters on the induction of extracellular lipase from SMVT 1, a PBD was employed to identify the significant ones. Typically, a complete factorial design involving eight variables would require 256 trial experiments. However, substituting it with a factorial randomized PBD significantly reduces the total trials to 12 while retaining important information regarding the main effects of the variables (Padhir and Modi 2013). The 12-run PBD, comprising 8 variables and 3 dummies alongside the corresponding lipase activity is represented in Table 2. The influence of the eight investigated parameters on lipase activity, in order of significance against the response based on the experimental design, is graphically depicted in the Half-normal plot and Pareto chart (Fig. 5a and b). According to the Pareto chart, peptone, olive oil, yeast extract, NaCl, pH, and medium volume (represented in orange) were identified as positive effects, while agitation speed and inoculum size were noted as negative effects (represented in blue) affecting lipase production. The lipase activity ranged from 3.75 to 30.45 U/mL during the PBD study, with run 12 resulting in a maximum response of 30.45 U/mL, underscoring the importance of the optimization process. ANOVA results of the PBD shown in Table 2 had an F-value of 40.9 and a p-value of < 0.05, implying the significance of the studied model. Notably, the four positive variables- olive oil, yeast extract, NaCl, and peptone- were identified as the significant parameters influencing lipase production. The effect of variables on enzyme activity was calculated based on the polynomial equation (Eq. 3):
The model’s p-value of < 0.0001 signifies its statistical significance, indicating only a 0.01% likelihood that the model’s F-value of 40.9 resulted from random noise. All factors were screened at 95% confidence levels considering their effects. The fit statistics displayed a coefficient of determination (R2) of 0.95, and the difference of less than 0.2 between the adjusted R2 and the predicted R2 shows that the designed model is adequate for demonstrating the relationship between the studied variables and the response. ANOVA revealed the p-values of olive oil, peptone, yeast extract, and NaCl to be ˂0.0001, 0.0065, 0.0003, and 0.0009, respectively (˂0.05), indicating these as the most significant variables influencing lipase induction. The results suggest that lipase induction is more influenced by nutritional factors than physical fermentation conditions, especially olive oil, the sole carbon source, and lipid substrate in the medium. Previous studies employing PBD have also emphasized the significance of nitrogen and carbon sources in lipase production. Venil et al. 2009 reported incubation time, yeast extract, calcium chloride, and pH as the significant factors affecting lipase from Serratia marcescens SB08. Similarly, PBD analysis revealed the importance of nitrogen sources like peptone, yeast extract, tryptone, and pH in lipase induction from Serratia sp. W3 (Eddehech et al. 2019). Moreover, the importance of carbon sources has been reported in previous studies. Cellulose and cottonseed oil, combined with K2HPO4, were found to impact lipase production in Nocardiopsis alba, and glucose, potassium, and manganese influenced lipase production in Serratia rubidaea, as identified by PBD (Nehal et al. 2019; Patel et al. 2021).
After identifying the significant influential factors as per PBD in the order of olive oil ˃ yeast extract ˃ NaCl ˃ peptone, they were subjected to optimization by RSM (CCD) to determine the optimal levels as PBD is inadequate for analyzing the mutual interactions of the designated variables (El-Naggar et al. 2016). The significant variables were varied while keeping the others constant, as utilized in the primary production media. For the four significant parameters, a CCD comprising 30 experiments was conducted, out of which 16 experiments were factorial, 8 were axial, and the remaining 6 were central, as previously mentioned. The 30-run CCD and the corresponding lipase activity, ranging from 11.31 to 54.91 U/mL are detailed in Table 3.
The results obtained from the response surface quadratic model CCD were subjected to ANOVA (Table 4). The F-value (370.68) and the p-value (< 0.05) underscored the significance of the CCD model. The lack of fit is an undesirable characteristic, and it was found insignificant for the present experimental model with an F-value of 1.49 and a p-value of 0.3457. Results of ANOVA showed the effect of different parameters and their interactions represented in the Fischer test. The linear terms- olive oil (A), NaCl (B), peptone (C), yeast extract (D); interactive terms- olive oil and NaCl (AB), olive oil and peptone (AC), NaCl and peptone (BC), NaCl and yeast extract (BD), and peptone and yeast extract (CD); and quadratic terms- olive oil (A²), NaCl (B²), peptone (C²), and yeast extracts (D²) had p-values < 0.05 and were the significant ones affecting lipase production. The interaction between olive oil and yeast extract (AD) with a p-value > 0.05 was insignificant. The most significant factor affecting lipase production was olive oil, followed by yeast extract and the quadratic effect of peptone and olive oil. The interactions between NaCl and peptone and peptone and yeast extract had significance but comparatively less compared to other significant model terms in lipase production. The F-value and p-value signify the effect of the involved terms on response, and the larger the F-value and smaller the p-value, the higher the significance (Mehmood et al. 2018). The R2 value used to resolve the quality of polynomial model fitness, and the F-test used for evaluating the statistical significance, suggested that the experimental results could be presented properly with the proposed quadratic polynomial model and is a significant one. The R² of the model was 0.9971, which means the model could effectively attribute to 99% of the variation in lipase production resulting from the selected significant variables. The R² value of more than 0.9 revealed the high correlation and relatedness between the experimental and predicted values (El-Naggar et al. 2016). The difference between the predicted R² and adjusted R² was less than 0.2, signifying that the model fits the experimental data. The R2 of a model can be a value from 0 to 1; 0 implies complete inadequacy, 1 the efficacy of directing the experimental design accurately, and R2 closer to 1 designates the improved prediction proficiency of the response (Adetunji and Olaniran 2018). An adequate precision ratio measuring the signal-to-noise ratio of 67.244 suggested the credibility of the model for optimization studies (Sahoo et al. 2021). The coefficient of variation (C.V.%) accounts for the reliability of the experimental design: the higher the C.V.%, the lower the reliability, and vice versa (El-Naggar et al. 2016; Sahoo et al. 2021). Analysis of the present model showed a lower C.V.% of 2.62. A C.V.% of ˂10 indicates the reproducibility of the experimental design (Adetunji and Olaniran 2018). An extent of how much a specific model fits every design point is given by the predicted residual sum of squares (PRESS). Model summary statistics indicated that the quadratic model exhibited the lowest PRESS value of 62.10. The smaller the PRESS, the better the fit between the model and the data points.
Multiple regression analysis of the experimental data resulted in a second-order quadratic polynomial equation (Eq. 4) for the lipase activity expressed in terms of A (olive oil), B (NaCl), C (peptone), and D (yeast extract), as follows:
where A, B, C, and D represent the linear terms signifying the main effects of individual variables on the response, while A², B², C², and D² account for the quadratic terms introducing nonlinear effects and curvature to the surface plot, with AB, AC, AD, BC, BD, and CD representing the interactive terms facilitating the visualization of variable combinations impact on lipase activity. Based on the coefficient estimate, the linear terms A, B, C, and D had more significance on lipase activity than their quadratic and interactive counterparts. Positive regression coefficients of the model terms signify a collaborative favourable influence, while negative coefficients indicate an adverse impact on lipase activity. The linear term of olive oil (A) exhibited the maximum significance. An increase in the concentration of olive oil, NaCl, peptone, or yeast extract, individually or in combination, is expected to lead to changes in lipase activity. However, considering the interactive and quadratic terms, the relationship might not follow a straightforward linear pattern, indicating the complexity and nonlinearity of how these factors collectively influence lipase activity.
Furthermore, 3D surface response curves were created using the model Eq. 4 to understand the interaction among the four specific variables and their optimal levels concerning lipase production (Figs. 6a–d and 7a and b). The 3D surface response plots illustrated enzyme activity on the z-axis, forming an uninterrupted surface with two independent variables (X1 and X2 on the x and y axes). Meanwhile, the levels of the remaining two variables, which represent actual factors can be set to specific levels or values. Values of the actual factors used for generating the plots are mentioned in the respective figure captions. The 3D surface response plots demonstrate the multifaceted interaction among the four variables, aiding in the identification of combinations potentially influencing enhanced or diminished lipase activity, thereby guiding process adjustments or improvements. Lipase activity variation is represented by a colour gradient or the height/depth of the surface, where red indicates the highest response and blue signifies the lowest. Typically, higher surfaces denote increased activity, while lower surfaces suggest decreased levels. The curved response surface plots depict the non-linear relationship between the four significant factors indicating that the effect of one factor might change based on the level of another factor. The simultaneous presence or increase of olive oil with NaCl and yeast extract (Fig. 6a and c), and NaCl with peptone (Fig. 6d) had a synergistic effect on lipase activity. Conversely, an antagonistic effect was observed when olive oil was simultaneously increased with peptone (Fig. 6b), and NaCl with yeast extract (Fig. 7a). Similarly, a decrease in lipase activity was noted when peptone was increased alongside yeast extract (Fig. 7b), displaying a lower impact than anticipated based on their individual effects. The surface response plots presented clear interactions between each pair of variables, emphasizing the significance of interactions among the selected four variables.
Three-dimensional response surface plot showing the interaction of significant factors resulting in lipase production of SMVT 1 a X1- olive oil and X2- NaCl, actual factors peptone and yeast extract- 0.75 g, b X1- olive oil and X2- peptone, actual factors NaCl and yeast extract- 1 g, c X1- olive oil and X2- yeast extract, actual factors NaCl and peptone- 1 g, and d X1- NaCl and X2- peptone, actual factors olive oil- 5 mL and yeast extract- 0.75 g
Three-dimensional response surface plot showing the interaction of significant factors resulting in lipase production of SMVT 1 a X1- NaCl and X2- yeast extract, actual factors olive oil- 5 mL and peptone- 0.87 g, b X1- yeast extract and X2- peptone, actual factors olive oil- 5 mL and NaCl- 1 g, c and d Three-dimensional response surface plot and contour plot showing the interaction of four significant factors resulting in optimized lipase production of SMVT 1, X1- olive oil and X2- NaCl, actual factors peptone- 0.81 g and yeast extract- 0.99 g, the optimized experimental lipase activity is flagged in the plots
The objective of the numerical optimization was to maximize the enzyme activity within the studied variable range. Among the 92 solutions predicted by Design-Expert, the one exhibiting the best desirability and response was selected. The predicted level of significant factors resulting in a corresponding response of 56.858 U/mL, given by Design-Expert -v11, was: olive oil- 5 mL, peptone- 0.817 g, yeast extract- 1 g, and NaCl- 0.888 g. The experiment was conducted in triplicate, and the resultant mean experimental response of 55.95 U/mL was in accordance with the predicted response, denoting a strong correlation validating the model. Optimal lipase production was observed when all the variables were above their central limits. Olive oil and yeast extract levels exhibited a direct relationship with the response, whereas peptone and NaCl augmented the response up to 0.8 g; beyond this threshold, enzyme activity declined. Figure 7c and d show the 3D surface interaction plot and contour plot of the optimized medium flagged with the optimized lipase activity suggested by the software. The 3D surface interaction plot was not parallel; instead, it curved, indicating that the variables’ interactions influencing lipase activity are interdependent. The elliptical contour plot signifies strong interactions between the selected variables, indicating that changes in one variable affect the response in a non-linear or conditional manner based on the level of the other variable. The contour lines further apart from each other indicate a more gradual change in lipase activity with interactions of the variables, with the maximum activity being represented in the red zone. Statistical optimization enhanced the lipase activity by 2.34-fold compared to the pre-optimization levels.
Similar enhancements in lipase production have been reported in prior studies employing various RSM experimental designs with different microorganisms such as Serratia marcescens, Nocardiopsis alba, Spingobacterium sp., Staphylococcus hominis (CCD), Bacillus aryabhattai (Face-centered central composite design), and Bacillus sp. (Central composite rotatable design) (Patel et al. 2021; Adetunji and Olaniran 2018; Sharma et al. 2014; Venil et al. 2009; Satti et al. 2019; Behera et al. 2019). The findings of the current study agree with previous research indicating that lipid substrates in the form of oil and nitrogen sources contribute to enhanced extracellular lipase production (Eddehech et al. 2019; Patel et al. 2021; Adetunji and Olaniran 2018; Vaisee et al. 2016; Satti et al. 2019). Eddehech et al. 2019 optimized peptone, yeast extract, tryptone, and pH using Box-Behnken design (BBD), resulting in a 2.6-fold enhancement in lipase activity from 5 mL to12.93 mL with Serratia sp. W3. They found that increased concentrations of nitrogen sources, peptone, and tryptone led to elevated lipase secretion. An increment of 6.29 times in lipase activity of 41.13 U/mL was obtained by optimizing the concentration of significant factors- glucose, potassium, and manganese- with the BBD using Serratia rubidaea (Nehal et al. 2019). An optimized lipase activity of 65.78 U/mL/min was obtained by optimizing the concentration of cottonseed oil (5.5%), cellulose (13.06 g), and K2HPO4 (2.75 g) using the CCD of RSM with Nocardiopsis alba (Patel et al. 2021). Vaisee et al. 2016 demonstrated a 1.83-fold enhancement in Bacillus cereus lipase activity with coriander seed extract/yeast extract (16.9 w/w), olive oil (2.37 g/L) and MgCl2 (24.23 mM) by RSM.
Conclusion
A novel mesophilic extracellular lipase-secreting strain, VT 1, was isolated and identified as Serratia marcescens based on standard screening and identification procedures. The lipase activity was successfully optimized by DOE using a combination of PBD and CCD of RSM with Design-Expert, version 11. PBD analysis showed the influential parameters including olive oil, peptone, yeast extract, and NaCl. CCD helped determine the optimal levels of these four significant parameters. Through optimization, a 2.34-fold increase in lipase induction was achieved compared to unoptimized conditions, resulting in an optimized activity of 55.95 U/mL. This study demonstrates the effective use of DOE for optimizing extracellular lipase synthesis. The optimized media composition derived from this study holds promise for the efficient and profitable production of SMVT 1 lipase in future studies.
Data availability
The data analyzed during the study will be made available on reasonable request from the corresponding author.
Abbreviations
- ANOVA:
-
Analysis of variance
- BBD:
-
Box-Behnken Design
- BLASTN:
-
Basic Local Alignment Search Tool for Nucleotide sequences
- CCD:
-
Central Composite Design
- DOE:
-
Design of Experiments
- MALDI-TOF MS:
-
Matrix-Assisted Laser Desorption/Ionization Time-of-Flight Mass Spectrometry
- MEGA11:
-
Molecular Evolutionary Genetics Analysis version 11
- MTCC:
-
Microbial Type Culture Collection and Gene Bank
- NCBI:
-
National Center for Biotechnology Information
- OFAT/OVAT:
-
One Factor/Variable at a Time
- PCR:
-
Polymerase Chain Reaction
- PBD:
-
Plackett-Burman Design
- PNPP:
-
4-Nitrophenyl palmitate/p-nitrophenyl palmitate
- PRESS:
-
Predicted Residual Sum of Squares
- rRNA:
-
Ribosomal ribonucleic acid
- ROA:
-
Rhodamine Olive Oil Agar
- RSM:
-
Response Surface Methodology
- SMVT 1:
-
Serratia marcescens VT 1
- TBA:
-
Tributyrin Agar
References
Abdullah AH, Nadhom BN, Al-Ammiri HH (2017) Isolation and identification of Serratia marcescens from Bovine Mastitis infections in Iraq and their susceptibility to antibiotics. J Entomol Zool Stud 5:489–492
Abdhul K, Sakthinarayanan K, Murugan M (2018) Isolation and identification of Serratia marcescens NASC 1 and optimization of its chitinase production. J Pharm Sci Res 10:1195–1197
Abdou MA (2003) Purification and partial characterization of psychrotrophic Serratia marcescens lipase. J Dairy Sci 86:127–132. https://doi.org/10.3168/jds.S0022-0302(03)73591-7
Abol Fotouh DM, Bayoumi RA, Hassan MA (2016) Production of thermoalkaliphilic lipase from Geobacillus thermoleovorans DA2 and application in leather industry. Enzyme Res 2016:9034364. https://doi.org/10.1155/2016/9034364
Abol-Fotouh D, AlHagar OE, Hassan MA (2021) Optimization, purification, and biochemical characterization of thermoalkaliphilic lipase from a novel Geobacillus stearothermophilus FMR12 for detergent formulations. Int J Biol Macromol 181:125–135. https://doi.org/10.1016/j.ijbiomac.2021.03.111
Adetunji AI, Olaniran AO (2018) Optimization of culture conditions for enhanced lipase production by an indigenous Bacillus aryabhattai SE3-PB using response surface methodology. Biotechnol Biotechnol Equip 32:1514–1526. https://doi.org/10.1080/13102818.2018.1514985
Adetunji AI, Olaniran AO (2021) Production strategies and biotechnological relevance of microbial lipases: a review. Braz J Microbiol 52:1257–1269. https://doi.org/10.1007/s42770-021-00503-5
Ahmad F, Wu FH (2012) High-resolution MALDI-TOF mass spectrometry of bacterial proteins using a Tris-EDTA buffer approach. Microchim Acta 176:311–316. https://doi.org/10.1007/s00604-011-0714
Ahmed HM, Mohamed SS, Moharam ME, El-bendary MA, Abd El-lateaf HA, Amin HA (2021) Statistical optimization of lipase production in solid-state fermentation by aspergillus tamarii NDA03a and application of the fermented solid as a biocatalyst for biodiesel production. Egypt Pharm J 20:23–32. https://doi.org/10.4103/epj.epj_30_20
Altschul SF, Gish W, Miller W, Myers EW, Lipman DJ (1990) Basic local alignment search tool. J Mol Biol 215:403–410. https://doi.org/10.1016/S0022-2836(05)80360-2
Aziz MMA, Elgammal EW, Ghitas RG (2020) Comparative study on modeling by neural networks and response surface methodology for better prediction and optimization of fermentation parameters: application on thermo-alkaline lipase production by Nocardiopsis sp. strain NRC/WN5. Biocatal Agric Biotechnol 25:101619. https://doi.org/10.1016/j.bcab.2020.101619
Begam SM, Pradeep SF, Pradeep VB (2012) Production, purification, characterization and applications of lipase from Serratia marcescens MBB05. Asian J Pharm Clin Res 5:0974–2441
Behera AR, Veluppal A, Dutta K (2019) Optimization of physical parameters for enhanced production of lipase from Staphylococcus hominis using response surface methodology. Environ Sci Pollut Res 26:34277–34284. https://doi.org/10.1007/s11356-019-04304-0
Castro-Ochoa L, Rodriguez-Gomez C, Valerio-Alfaro G, Oliart Ros R (2005) Screening, purification, and characterization of thermoalkalophilic lipase produced by Bacillus thermoleovorans CCR11. Enzyme Microb Technol 37:648–654. https://doi.org/10.1016/j.enzmictec.2005.06.003
Chu D, Barnes DJ (2016) The lag-phase during diauxic growth is a trade-off between fast adaptation and high growth rate. Sci rep 6:1–5. https://doi.org/10.1038/srep2519
Drummond AJ, Ashton B, Buxton S, Cheung M, Cooper A, Heled J, Kearse M, Moir R, StonesHavas S, Sturrock S, Thierer T, Wilson A (2010) Geneious v. 5.1. http://www.geneious.com. Accessed 11 Jun 2019
Duzhak AB, Panfilova ZI, Vasyunina EA (2000) Isolation and characterization of extracellular lipase preparations from wild type V-10 and mutant M-1 Serratia marcescens strains. Appl Biochem Microbiol 36:344–352. https://doi.org/10.1007/BF02738041
Eddehech A, Zarai Z, Aloui F, Smichi N, Noiriel A, Abousalhamb A, Gargouria Y (2019) Production, purification, and biochemical characterization of a thermoactive, alkaline lipase from a newly isolated Serratia sp. W3 Tunisian strain. Int J Biol Macromol 123:792–800. https://doi.org/10.1016/j.ijbiomac.2018.11.050
El-Naggar NE, El-Shweihy NM, El-Ewasy SM (2016) Identification and statistical optimization of fermentation conditions for a newly isolated extracellular cholesterol oxidase-producing Streptomyces cavourensis strain NEAE-42. BMC Microbiol 16:1–20. https://doi.org/10.1186/s12866-016-0830-4
Gupta U, Kar R (2009) Xylanase production by a thermo-tolerant Bacillus species under solid-state and submerged fermentation. Braz Arch Biol Technol 52:1363–1371. https://doi.org/10.1590/S1516-89132009000600007
Gupta B, Gupta K, Mukherjee S (2013) Lipase production by Serratia marcescens strain SN5gR isolated from the scat of lion-tailed macaque (Macaca silenus) in Silent Valley National Park, a biodiversity hotspot in India. Ann Microbiol 63:649–659. https://doi.org/10.1007/s13213-012-0515-7
Kedney GM, Strunk BK, Giaquinto ML, Wagner AJ, Pollack S, Patton AW (2007) Identification of bacteria using matrix-assisted laser desorption ionization time-of-flight mass spectrometry. Biochem Mol Biol Educ 35:425–433. https://doi.org/10.1002/bmb.105
Kouker G, Jaeger EK (1987) Specific and sensitive plate assay for bacterial lipases. Appl Environ Microbiol 53:211–213. https://doi.org/10.1128/aem.53.1.211-213.1987
Kumar A, Parihar SS, Batra N (2012) Enrichment, isolation and optimization of lipase-producing Staphylococcus sp. from oil mill waste (oil cake). J Exp Sci 3:26–30
Lowry OH, Rosebrough NJ, Farr LA, Randall RJ (1951) Protein measurement with the Folin phenol reagent. J Biol Chem 193:265–275
Luz BD, Sarrouh B, Bicas JL, Lofrano RC (2021) Lipase production by microorganisms isolated from the Serra De Ouro Branco State Park. An Acad Bras Cienc 93(1). https://doi.org/10.1590/0001-3765202120190672
Maier T, Klepel S, Renner U, Kostrzewa M (2006) Fast and reliable MALDI-TOF MS-based microorganism identification. Nat Methods 3:1–2. https://doi.org/10.1038/nmeth870
Mehmood T, Ahmed A, Ahmad A, Ahmad MS, Sandhu MA (2018) Optimization of mixed surfactants-based β-carotene nanoemulsions using response surface methodology: an ultrasonic homogenization approach. Food Chem 253:179–184. https://doi.org/10.1016/j.foodchem.2018.01.136
Nadeem F, Mehmood T, Anwar Z, Saeed S, Bilal M, Meer B (2021) Optimization of bioprocess steps through response surface methodology for the production of immobilized lipase using Chaetomium Globosum via solid-state fermentation. Biomass Convers Biorefinery 21:1–12. https://doi.org/10.1007/s13399-021-01752-y
Nehal F, Sahnoun M, Dab A, Sebaihia M, Bejar S, Jaouadi B (2019) Production optimization, characterization, and covalent immobilization of a thermophilic Serratia rubidaea lipase isolated from an Algerian oil waste. Mol Biol Rep 46:3167–3181. https://doi.org/10.1007/s11033-019-04774-y
Ng W (2018) Conserved mass peaks in MALDI-TOF mass spectra of bacterial species at the genus and species levels. PeerJ Prepr 6:e3524v2. https://doi.org/10.7287/peerj.preprints.3524v2
Padhir AR, Modi HA (2013) Optimization of lipase production by Saccharomonospora azurea using plackett-burman design and response surface methodology. IJBTR 3:59–66
Patel R, Prajapati V, Trivedi U, Patel K (2020) Optimization of organic solvent-tolerant lipase production by Acinetobacter sp. UBT1 using deoiled castor seed cake. 3 Biotech 10:508. https://doi.org/10.1007/s13205-020-02501-0
Patel GB, Shah KR, Shindhal T, Rakholiya P, Varjani S (2021) Process parameter studies by central composite design of response surface methodology for lipase activity of newly obtained Actinomycete. Environ Technol Innov 23:101724. https://doi.org/10.1016/j.eti.2021.101724
Pereira LM, Milan TM, Tapia-Blacido DR (2021) Using response surface methodology (RSM) to optimize 2G bioethanol production: a review. Biomass Bioenergy 151:106166. https://doi.org/10.1016/j.biombioe.2021.106166
Prasad MP (2013) Production of extracellular lipase by Serratia marcescens isolated from industrial effluent. Int J Curr Res Acad Rev 1:26–32
Priyanka P, Kinsella GK, Henehan GT, Ryan BJ (2020) Isolation and characterization of a novel thermo-solvent-stable lipase from Pseudomonas brenneri and its application in biodiesel synthesis. Biocatal Agric Biotechnol 29:101806. https://doi.org/10.1016/j.bcab.2020.101806
Ramnath L, Sithole B, Govinden R (2017) Identification of lipolytic enzymes isolated from bacteria indigenous to Eucalyptus wood species for application in the pulping industry. Biotechnol Rep 15:114–124. https://doi.org/10.1016/j.btre.2017.07.004
Saha J, Chaki MG, Karmakar S, Chatterjee A, Pal A (2023) Effect of different heavy metals on lipase production by a multiple heavy metal-resistant Pseudomonas aeruginosa strain isolated from arable land. Biologia 78:2975–2985. https://doi.org/10.1007/s11756-023-01465-9
Sahoo RK, Kumari KS, Sahoo S, Das A, Gaur M, Dey S, Mohanty S, Subudhi E (2021) Bio-statistical optimization of lipase production by thermophilic Pseudomonas formosensis and its application on oral biofilm degradation. Biocatal Agric Biotechnol 33:101969. https://doi.org/10.1016/j.bcab.2021.101969
Satti SM, Abbasi AM, Marsh TL, Auras R, Hasan F, Badshah M, Farman M, Shah AA (2019) Statistical optimization of lipase production from Sphingobacterium sp. strain S2 and evaluation of enzymatic depolymerization of poly (lactic acid) at mesophilic temperature. Polym Degrad Stab 160:1–13. https://doi.org/10.1016/j.polymdegradstab.2018.11.030
Selvamohan T, Ramadas V, Sathya A (2012) Optimization of lipase enzyme activity produced by Bacillus amyloliquefaciens isolated from rock lobster Panlirus homarus. IJMER 2:4231–4234
Shahedi M, Yousefi M, Habibi Z, Mohammadi M, Ashabi MA (2019) Co-immobilization of Rhizomucor miehei lipase and Candida Antarctica lipase B and optimization of biocatalytic biodiesel production from palm oil using response surface methodology. Renew Energy 141:847–857. https://doi.org/10.1016/j.renene.2019.04.042
Sharma D, Kumbhar BK, Verma AK, Tewari L (2014) Optimization of critical growth parameters for enhancing extracellular lipase production by alkalophilic Bacillus sp. Biocatal Agric Biotechnol 3:205–211. https://doi.org/10.1016/j.bcab.2014.04.004
Smith AC, Hussey MA (2005) Gram stain protocols. Am Soc Microbiol 30:14
Sztajer H, Maliszewska I, Wieczorek J (1988) Production of exogenous lipases by bacteria, fungi and actinomycetes. Enzyme Microb Technol 10:492–497. https://doi.org/10.1016/0141-0229(88)90027-0
Tamura K, Stecher G, Kumar S (2021) MEGA11: molecular evolutionary genetics analysis version 11. Mol Biol Evol 38:3022–3027. https://doi.org/10.1093/molbev/msab120
Triyaswati D, Ilmi M (2020) Lipase-producing filamentous Fungi from non-dairy Creamer Industrial Waste. Microbiol Biotechnol Lett 48:167–178. https://doi.org/10.4014/mbl.1912.12018
Vasiee A, Behbahani BA, Yazdi FT, Moradi S (2016) Optimization of the production conditions of the lipase produced by Bacillus cereus from rice flour through Plackett-Burman Design (PBD) and response surface methodology (RSM). Microb Pathog 101:36–43. https://doi.org/10.1016/j.micpath.2016.10.020
Venil C, Sangeetha KN, Lakshmanaperumalsamy P (2009) Statistical optimization of medium components for the production of lipase by Serratia marcescens SB08. Internet J Microbiol 7(1). https://api.semanticscholar.org/CorpusID:59334795
Vivek K, Sandhia GS, Subramaniyan S (2021) A study on the culture variables affecting the production of Extracellular lipase by Serratia marcescens VT1. Res J Agric Sci 12:1773–1779
Vivek K, Sandhia GS, Subramaniyan S (2022) Extremophilic lipases for industrial applications: a general review. Biotechnol Adv 7:108002. https://doi.org/10.1016/j.biotechadv.2022.108002
Vivek K, Sandhia GS, Subramaniyan S (2023) Purification and characterization of a psychrophilic lipase from Serratia marcescens VT 1 and its application in methyl ester synthesis. Bioresour Technol Rep 22:101443. https://doi.org/10.1016/j.biteb.2023.101443
Wang K, Guo Q, Froehlich JE, Hersh HL, Zienkiewicz A, Howe GA, Benning C (2018) Two abscisic acid-responsive plastid lipase genes involved in jasmonic acid biosynthesis in Arabidopsis thaliana. Plant Cell 30:1006–1022. https://doi.org/10.1105/tpc.18.00250
Yagiz F, Kazan D, Akin AN (2007) Biodiesel production from waste oils by using lipase immobilized on hydrotalcite and zeolites. Chem Eng J 134:262–267. https://doi.org/10.1016/j.cej.2007.03.041
Zaki HN, Saeed ES (2012) Production, purification and characterization of extra cellular lipase from Serratia marcescens and its potential activity for hydrolysis of edible oils. ANJS 15:94–102. https://doi.org/10.22401/JNUS.15.1.14
Zhang Y, Shang R, Zhang J, Li J, Zhu G, Yao M, Sun J, Shen Z (2020) Isolation and identification of two Serratia marcescens strains from silkworm, Bombyx mori. Antonie Van Leeuwenhoek 113:1313–1321. https://doi.org/10.1007/s10482-020-01442-1
Acknowledgements
The author thanks the Principal and Department of Botany, University College, Palayam, Thiruvananthapuram, for providing laboratory facilities. The author is grateful to Dr. Subramaniyan S, Principal and Professor, Government Arts College, Thiruvananthapuram, and Dr. Sandhia G.S, Principal and Professor, Government College, Kariavattom, Thiruvananthapuram, for all their guidance and support during the period of work. The author is thankful to the Rajiv Gandhi Centre for Biotechnology, Thiruvananthapuram, and Microbial Type Culture Collection and Gene Bank (MTCC), Institute of Microbial Technology (IMTECH), Chandigarh, India, for the identification of microorganisms. The author is also thankful to the University of Kerala, Thiruvananthapuram, for the fund provided during work.
Funding
The present work was funded by the University of Kerala, Palayam, Thiruvananthapuram.
Author information
Authors and Affiliations
Contributions
Vivek K conceptualized the study, collected the literature and methodology, performed the experiments, wrote, and edited the manuscript.
Corresponding author
Ethics declarations
Ethics approval
Not applicable.
Consent to participate
Not applicable.
Consent to publish
Not applicable.
Competing interests
The author hereby declare that he has no relevant financial or non-financial competing interest to disclose.
Additional information
Publisher’s Note
Springer Nature remains neutral with regard to jurisdictional claims in published maps and institutional affiliations.
Rights and permissions
Springer Nature or its licensor (e.g. a society or other partner) holds exclusive rights to this article under a publishing agreement with the author(s) or other rightsholder(s); author self-archiving of the accepted manuscript version of this article is solely governed by the terms of such publishing agreement and applicable law.
About this article
Cite this article
Krishnankutty, V. Optimization of lipase production by response surface methodology from Serratia marcescens VT 1 isolated from oil contaminated soil. Biologia 79, 1471–1486 (2024). https://doi.org/10.1007/s11756-024-01614-8
Received:
Accepted:
Published:
Issue Date:
DOI: https://doi.org/10.1007/s11756-024-01614-8